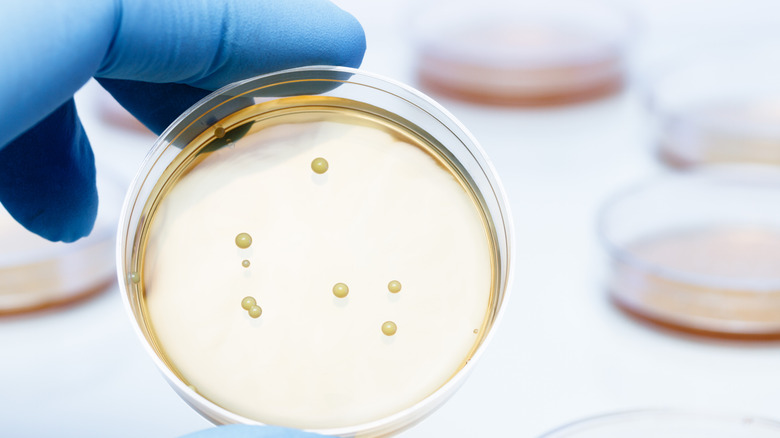
Scientist holds petri dish.

Can Probiotics Boost Your Vaginal Health?
If you have a vagina and you've opened a social media app this year, you've probably seen targeted ads for probiotics promising to perfect your vaginal microbiome. Suppose you're the owner of a vagina that tends to cause trouble in the form of recurrent yeast infections, bacterial vaginosis, or urinary tract infections. You'd certainly want the answer to this burning (no pun intended) question, like, yesterday.
Even Goop, which once brought vaginal steaming to the mainstream masses, has jumped on the bandwagon. But is there any reality to the idea that a daily dose of these beneficial bacteria can shift vaginal flora in the right direction enough to prevent the imbalances that can be caused by everyday life? Unprotected sex, hormone fluctuations, menstruating, and periods of less-than-ideal hygiene can all be enough to throw off your bacterial ratio. Let's uncover the facts to reveal whether probiotics are powerful enough to maintain vaginal balance or if we've just been sucked into another marketing campaign.
Introducing probiotic MVP lactobacillus
When it comes to the possibility of certain bacteria benefiting vaginal health, Lactobacillus is first in line. This genus is the most well-studied when it comes to the scientifically proven benefits of probiotics on gut health. While there are over 200 species and sub-species of Lactobacillus, two have been singled out in a human trial by Osel, Inc. and the University of California, San Francisco for their potential benefits to vaginal bacterial balance: lactobacillus crispatus and lactobacillus rhamnosis (via ClinicalTrials.gov).
Lactobacillus crispatus naturally occurs in a healthy vaginal environment and creates hydrogen peroxide and other anti-microbial compounds as byproducts. The strain is widely available in supplement form and is added to certain fermented food products. However, it is not as commonly available in food form as lactobacillus rhamnosis.
Meanwhile, Lactobacillus rhamnosis is typically found inside the intestines and converts lactose sugars into lactic acid. It is widely available in many brands of fermented or aged foods and drinks like yogurt, cheese, kombucha, sauerkraut, and kimchi. It can also be found in many probiotic supplements, often in combination with lactose crispatus.
What the research shows
Scientific research on the effects of probiotic consumption on vaginal health is currently only in its infancy and is still considered to be experimental in nature. So far, two facts have been proven in an official study in the scientific journal Microorganisms. One is that certain strains of Lactobacillus bacteria have the ability to attach themselves to both vaginal and cervical cells. The other is that they can directly combat invading pathogens that could cause common types of vaginal infections through their production of anti-microbial compounds.
These are incredibly promising developments, especially for those who struggle to maintain a healthy vaginal microbiome and an appropriately acidic pH level. Whether you choose to look for foods that naturally offer probiotics or take the plunge and invest in a high-quality supplement, there's a good chance your vaginal (and gut) health will benefit. At the very least, there is an extremely low chance of experiencing any negative side effects (via WebMD), so why not give it a try?